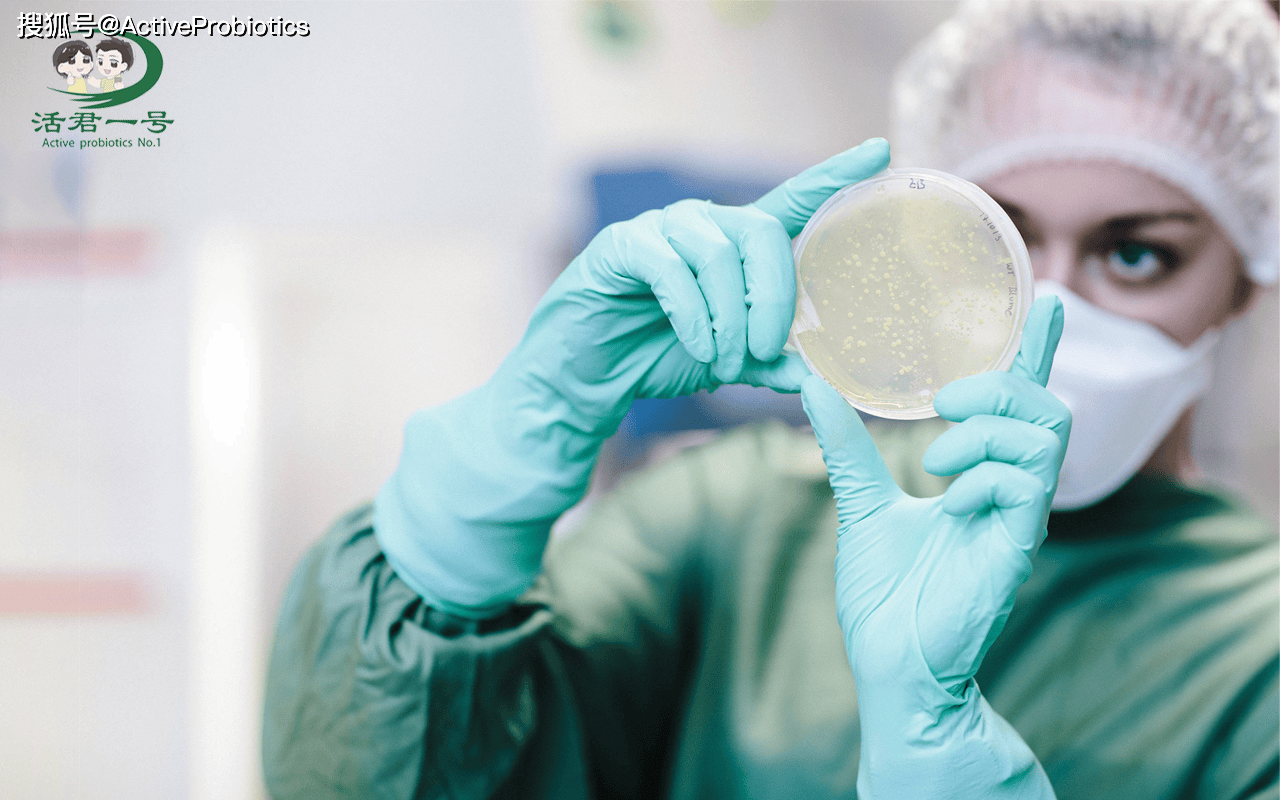
casei21的健康作用及适用人群?

平原县齐殿君

「心理健康」公安部战时心理健康服务工作队赴基层送健康
图片尺寸640x426
学校召开第二届学术委员会第九次会议
图片尺寸1268x840
中国医科大学附属第一医院
图片尺寸810x810
溃疡性结肠炎自愈新进展,三大发明专利菌株上市引关注!
图片尺寸1000x450
溃疡性结肠炎自愈新进展,三大发明专利菌株上市引关注!
图片尺寸790x1280
一名中学老师的溃疡性结肠炎自愈攻略:益生菌前六强联合用药!
图片尺寸500x404一名中学老师的溃疡性结肠炎自愈攻略:益生菌前六强联合用药!
图片尺寸500x404
徐付彪)平原县人大常委会原第一副主任,党组书记齐殿君涉嫌严重违纪
图片尺寸770x439
三大发明专利菌株上市,事关溃疡性结肠炎自愈与复发风险
图片尺寸660x1070
三大发明专利菌株上市,事关溃疡性结肠炎自愈与复发风险
图片尺寸500x225三大发明专利菌株上市,事关溃疡性结肠炎自愈与复发风险
图片尺寸500x225
一名中学老师的溃疡性结肠炎自愈攻略:益生菌前六强联合用药!
图片尺寸500x225
casei21的健康作用及适用人群?
图片尺寸1280x800